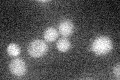
YGL248W
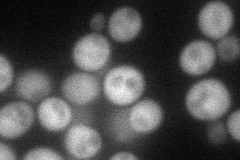
YGL248W
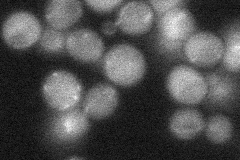
YGL248W
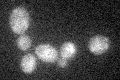
YGL248W

View description
Low-affinity cyclic AMP phosphodiesterase, controls glucose and intracellular acidification-induced cAMP signaling, target of the cAMP-protein kinase A (PKA) pathway; glucose induces transcription and inhibits translation
Localization:
Intensity:
Fold change:
Significance:
-
C’ GFP library in SD
below threshold16.84 -
N' NOP1pr-GFP in SD
cytosol59.3101 -
N' TEF2pr-mCherry in SD

cytosol0 -
N' NATIVEpr-GFP in SD
cytosol27.8032 -
N' TEF2pr-VC and Cyto-VN in SD

#N/A0 -
C’ GFP library in SD+DTT

cytosol17.961.06No -
C’ GFP library in SD+H2O2
cytosol21.631.28No -
C’ GFP library in Starvation Media

cytosol33.091.96No -
C’ GFP library on the background of Pup2-DaMP

N/A -
C’ GFP library on the background of CCT mutant

N/A0N/AYes
